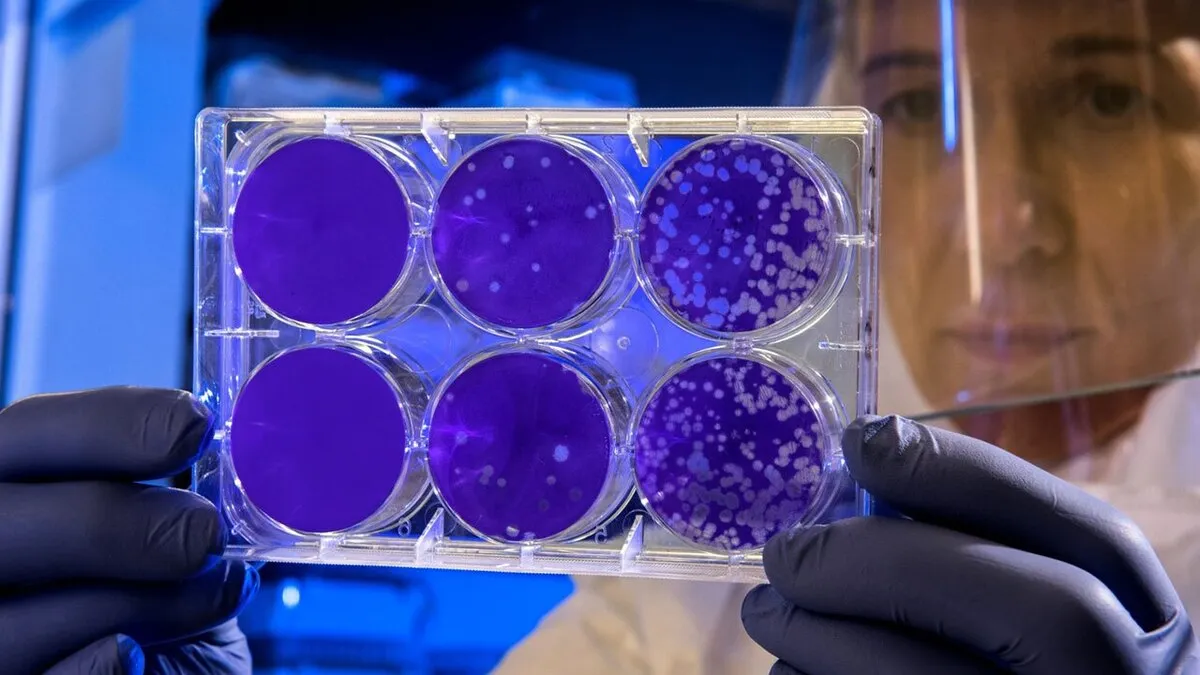

محققان در مقالهای که به تازگی منتشر شده، جزئیاتی درباره تهیه نانوذرات پلی فسفات کلسیم تقویت شده با نانوذرات نقره منتشر کردند. محققان با تمرکز بر خصوصیات فیزیکوشیمیایی این نانوذرات، توصیف کاملی از نانوذرات آماده شده ارائه کردند. یکی از نکات جالب توجه که در این مقاله به آن اشاره شده این است که با افزایش درصد نقره، در اندازه ذرات و پایداری حرارتی نانوذرات بهبود قابل توجهی مشاهده میشود.
یکی از یافتههای کلیدی این مطالعه، فعالیت ضد باکتریایی قابل توجه این نانوذرات است. بررسیهای محققان نشان داد که این نانوذرات را میتوان به عنوان تغییر دهنده بالقوه بازی در مبارزه با عفونتهای باکتریایی متعدد، به ویژه در بهبود زخم و عفونتهای بافت استخوان استفاده کرد.
علاوه بر این، نانوذرات حتی با بالاترین میزان نقره نیز، رفتار غیر سیتوتوکسیک نشان دادند، در واقع افزایش نقره موجب اثرات سمی روی این نانوذرات نمیشود که این موضوع در بررسی از منظر ایمنی و اثربخشی در پزشکی اهمیت زیادی دارد.
پس از آزمایشهای دقیق، محققان این پروژه دریافتند که سه درصد نقره به عنوان عامل تقویت کننده در ساختار این نانوذرات میتواند غلظت بهینه برای کاربردهای زیستپزشکی باشد به طوری که به راحتی و خیالی آسوده بتوان از آن در کارهای بالینی از آن استفاده نمود. این میزان تقویت با نقره رفتار سمی برای سلول به دنبال ندارد و به ترمیم زخمها کمک شایانی میکند.
نتایج این پروژه گامی مهم در حوزه تحقیقات زیستپزشکی است چرا که یک نانوذرات تقویت شده با نقره را معرفی میکند که پتانسیل استفاده در پزشکی را داشته و در عین حال میتواند جایگزین آنتیبیوتیکها شود.
البته برای استفاده از آن در کلینیکها هنوز نیاز به تحقیقات بیشتر روی این نانوذره وجود دارد تا جوانب مختلف آن بررسی شود.